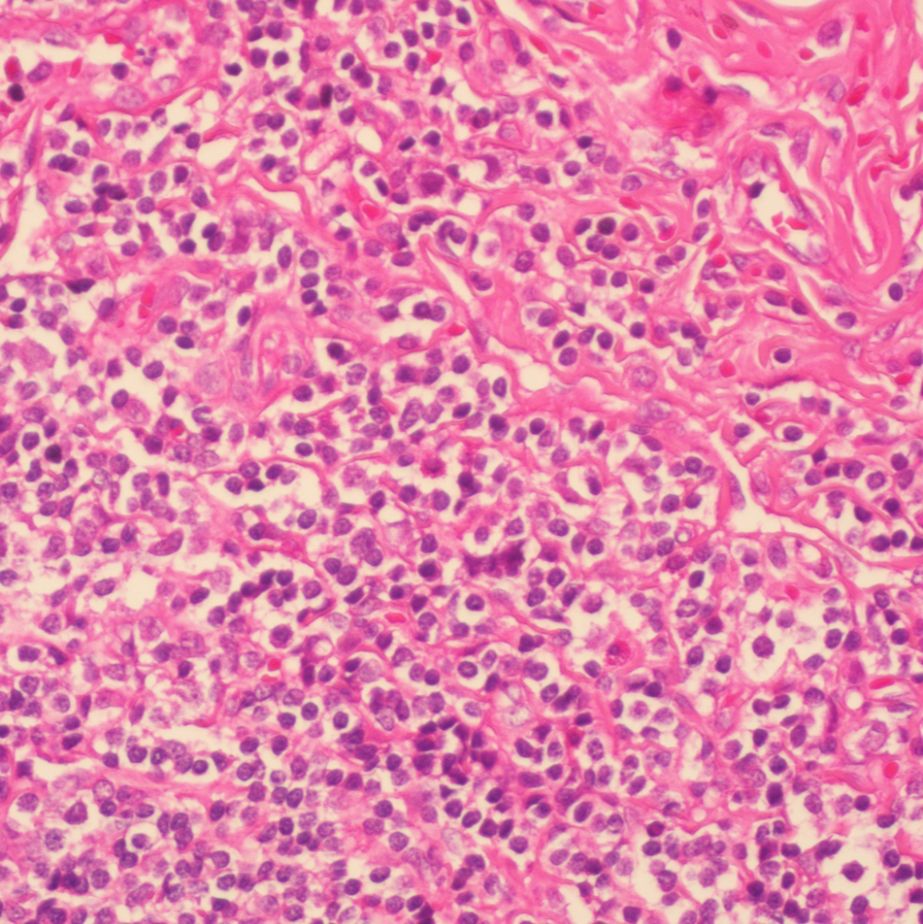
中杉金桥 BSBA-4021A 苏木素染色液

相关产品推荐更多 >
万千商家帮你免费找货
0 人在求购买到急需产品
- 详细信息
- 文献和实验
- 技术资料
- 库存:
99
- 供应商:
北京云肽生物科技有限公司
我们北京云肽生物科技有限公司作为 中杉金桥 公司的特约经销商为客户提供,正规进口,保证原装正品,货期稳定,折扣好的服务标准。
北京中杉金桥生物技术有限公司建有专业的免疫组化实验室、分子病理实验室,2016年成为中国医学装备协会病理装备分会 shou jia 认证的免疫组化专项培训基地和分子病理培训基地。长期以来,公司积极参加病理行业协(学)会、认真落实行业政策,成为具有行业责任感和社会责任感的企业。公司获得中国医疗器械行业协会病理专业委员会、中国医学装备协会病理装备分会和北京肿瘤病理精准诊断研究会常务理事会员单位。
未来,我们将继续弘扬“立德、敬业”的企业精神,以高度的社会责任感和使命感,开拓创新、锐意进取。坚持以科学发展观为指导,以解决客户需求为目标,全心全意为用户提供 zui you 质的产品和服务。
中杉金桥 BSBA-4021A 苏木素染色液,产品简介:
产品品牌:中杉金桥
产品货号:BSBA-4021A
产品名称:苏木素染色液
产品规格:500ML
中杉金桥 BSBA-4021A 苏木素染色液,产品说明:
分类: 检测系统
子分类:特染产品
规格:500ml
预期用途: 用于各种细胞、组织石蜡切片、冰冻切片、火棉胶切片、树脂切片、涂片、印片的染色
储存/效期: 1年半
产品订购信息:
BSBA-4021A 中杉金桥 苏木素染色液 500ML
风险提示:丁香通仅作为第三方平台,为商家信息发布提供平台空间。用户咨询产品时请注意保护个人信息及财产安全,合理判断,谨慎选购商品,商家和用户对交易行为负责。对于医疗器械类产品,请先查证核实企业经营资质和医疗器械产品注册证情况。
 文献和实验
文献和实验分别为0.3%双氧水和0.3%Triton X-100混合而成。配制方法是先用微波加热的36 ml PBS,再接着加120 ul Triton X-100,并加热一会儿,冷却至临用前加0.4 ml 30%H2O2。4、5%羊血清或封闭血清,用PBS稀释。5、含0.03%H2O2的0.05%DAB(避光):用20×DAB(1%,10 mg/ml)5 ul+0.1 ul 30% H2O2+95 ul PBS。6、一抗用PBS稀释(也可用抗体稀释液),二抗用中杉金桥的SP染色试剂盒。7、Xylene、梯度
;DAB 显色时间很短(如几秒或几十秒)就出现很深的棕褐色,这很可能说明你的抗体浓度过高或抗体孵育时间过长,需要下调抗体浓度或缩短你的抗体孵育时间;此外,若很短时间就出现背景很深,还有可能你前面的封闭非特异性蛋白不全,需要延长封闭时间;DAB 显色时间很长(如超过十几分钟)才出现阳性染色,一方面可能说明你的抗体浓度过低或孵育时间过短(最好一抗 4 ℃过夜);另一方面就是封闭时间过长。 12)复染 目的是形成细胞轮廓,从而更好地对目标蛋白进行定位,经常用苏木素复染(胞
隆抗体]、生物素化山羊抗小鼠IgG、试剂SABC,最后DAB显色,苏木素复染,酒精梯度脱水,二甲苯透明,中性树胶封片,显微镜下观察。2 结果 2.1 体外培养的胎儿脐动脉血管平滑肌细胞的形态观察 实验中观察到脐动脉组织块贴壁后5~7d可见有细胞以垂直方向从组织块周围游走出来(见图1),但并不是所有的组织块周围都有细胞游出,离组织块较远的区域也可以看到细胞,此为平滑肌细胞的漂移性生长特性(见图2),细胞形态多样,大小不一,多为长梭形、菱形或星形; 9~11 d细胞进入对数生长期,细胞生长加速,部分
 技术资料
技术资料暂无技术资料 索取技术资料

![AAT Bioquest 2555 APC [Allophycocyanin]](https://img1.dxycdn.com/2023/1020/112/0042242748418625171-14.jpg!wh200)



